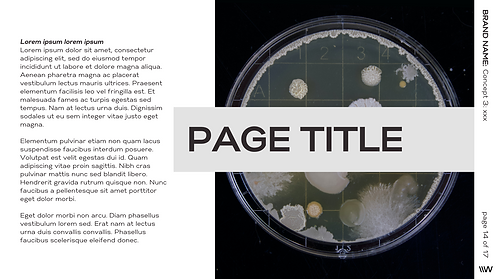

Document Design














SAMPLE STORYBOARD
DESCRIPTION:
This is an example storyboard for a showreel. This is a typical storyboard for a text animation brand video with stock footage in a mixed media style. However my storyboards differ depending on the medium used, for example if clips are needed to be sourced beforehand either from existing footage, stock footage, or a shoot, or depending on video style
CREATIVE CONCEPTS
DESCRIPTION;
For each creative concept document, I will outline each concept with a description, sample image moodboard to illustrate visual style, and sample videos to represent the concept. I will also include mockup stills when complex concepts need more creative explanation for the client.
​
The documents included here are for example purpose only. Each concept is filled in with grouped sample imagery that could represent a creative concept in order to illustrate the typical look and feel of these documents.

CREATIVE BRIEFING
DESCRIPTION:
This a creative briefing document I created to be sent to all clients from Wooshii to brief us on their video projects. This is sent out as an editable PDF document.













DATA VISUALISATION
DESCRIPTION:
These are example of data visualisation work. Each project is different but these samples illustrate a couple of avenues of data driven design work.
